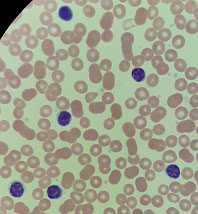

Lymphocytes: polymorphisme et clonalité
Les lymphocytes remplissent un rôle central dans l'immunité adaptative. Chacun peut réagir avec un antigène particulier et remplir une fonction soit dans l'activation, la régulation et la mémoire de la réponse immunitaire, ou directement dans l'attaque, que ce soit par la destruction directe des cellules par les lymphocytes T et NK, ou la sécrétion d'anticorps par les lymphocytes B et les plasmocytes.
Les lymphocytes normaux ont une morphologie très simple: une cellule ronde, petite, avec un noyau à la chromatine dense proportionnellement gros, et peu de cytoplasme.
Malgré tout, on y voit un peu de variété: certaines cellules sont plus grosses que les autres, elles peuvent être ovales, et contiennent ou non des granulations azurophiles (colorées en rouge au Wright-Giemsa). On verra parfois des lymphocytes à la chromatine plus fine, et au cytoplasme basophile.
C'est que ce qu'on appelle globalement des lymphocytes comprennent plusieurs lignées de cellules, et celles-ci peuvent aussi changer d'aspect selon leur activité du moment.
Les lymphocytes T sont petits, ronds et ont très peu de cytoplasme. Ils comptent pour la majorité des petits lymphocytes.
Les lymphocytes B et NK forment la majorité des grands lymphocytes. Leur cytoplasme est plus abondant; la cellule est souvent ovale avec un noyau excentrique.
Les lymphocytes réactionnels peuvent provenir de n'importe quelle lignée, mais sont modifiés pour une activité plus intense. Les traits suivants peuvent être présents en diverses combinaisons:
- La chromatine est moins dense, car la cellule doit transcrire davantage de son ADN.
- Le cytoplasme est basophile, car une plus grande quantité de protéines est synthétisée.
- La cellule se moule autour des globules rouges l'entourant.
- Dans le cas du lymphocyte B, la réapparition de traits immatures (apparence proche du lymphoblaste) précède la transformation en plasmocyte.
On ne peut pas classer les lymphocytes par leur morphologie seule, car celle-ci demeure trop proche pour exclure les variations entre cellules d'une même lignée.

Commentaires
Enregistrer un commentaire